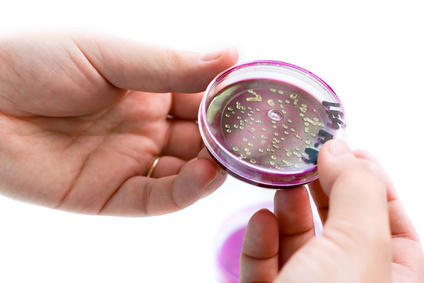

"超级菌"对大多数传统抗生素具有耐药性,感染患者后可引起疾病传染,但是,这一"超级菌"也有弱点,加拿大研究小组的科学家发现,包裹混合抗生剂的脂质体能提高药物对抗药性细菌的杀伤作用。
相关的研究发表在FASEB网络期刊。
麦克马斯特大学(McMaster University)生化和生物医学研究所理查德博士参与这一研究,他说,这一研究有助于克服耐药性细菌引起致命危害,尤其在医院,后者不断引起越来越多的临床问题。
Epand及其同事开展了一项试验——用广谱耐药性的大肠杆菌(E. coli)注射实验组小鼠,致死剂量注射后的小鼠再分别接受传统的混合药物和脂质体包裹的混合药物治疗。试验结果表明,脂质体混合药物有更好的治疗效果,它能有效地克制大肠杆菌引起的细胞毒害机制,表现在有较高的小鼠存活率。
研究还表明,抗生剂新家族——oligo-acyl-lysyls——是不同药物和脂质包裹而成的组装体,具有相同的药效。这一技术可以开发出其他应用的平台。
“正如我们看到的那样,近来,德国大肠杆菌病情大爆发,该细菌变异成耐受抗生素的超级细菌,多亏了脂质体介导的抗生素治疗,这一光谱耐药性的细菌才没有酿成更大的灾难。”FASEB杂志主编Gerald Weissmann博士说。(生物探索译)
大肠埃希氏菌(大肠杆菌)
生物探索推荐英文原文
Scientists Develop a Fatty 'Kryptonite' to Defeat Multidrug-Resistant 'Super Bugs'
"Super bugs," which can cause wide-spread disease and may be resistant to most, if not all, conventional antibiotics, still have their weaknesses. A team of Canadian scientists discovered that specific mixtures of antimicrobial agents presented in lipid (fatty) mixtures can significantly boost the effectiveness of those agents to kill the resistant bacteria.
This discovery was published online in The FASEB Journal.
According to a researcher involved in the study, Richard Epand, Ph.D. from the Department of Biochemistry and Biomedical Science at McMaster University in Hamilton, Ontario, Canada, "This study may contribute to overcoming the lethal effects of drug resistant bacteria that is becoming an increasing clinical problem, particularly in hospitals."
To make their discovery, Epand and colleagues conducted experiments using groups of mice infected with lethal doses of multidrug-resistant Escherichia coli (E. coli). Researchers then treated the mice with conventional drug combinations or drug combinations encapsulated in lipid mixtures. They found that certain lipid mixtures caused the drugs to act together in a synergistic manner. In this form, the drugs were much more effective in increasing the survival rate of the mice because they overcame the cellular mechanisms used by these bacteria to defeat therapeutic agents.
This study also demonstrated a novel use of a new family of antimicrobial agents called oligo-acyl-lysyls, which have the potential to be combined with other drugs and lipid mixtures with similar properties to yield a platform for other specific applications.
"As we've seen in the recent E. coli outbreak in Germany, bacteria can mutate to become super bugs that resist antibiotics," said Gerald Weissmann, M.D., Editor-in-Chief of The FASEB Journal. "Thanks to this new, lipid-based antibiotic therapy, multidrug-resistant bacteria may begin to look more like Jimmy Olsen and a lot less like Superman."







